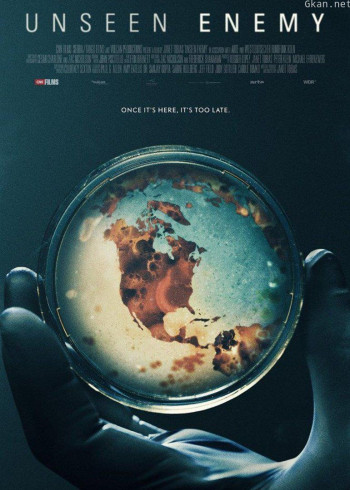
看不见的敌人

2017 | 正片

女神厨房
2017 | 正片

破千者之天下公敌
2017 | 正片

末日之恋
2017 | 正片

男模的秘密
2017 | 正片
豆瓣:4.2分

魔游纪5:宿命之争
2017 | 正片
豆瓣:7.6分

飘离号
2017 | 正片
豆瓣:6.9分

你从未在此
2017 | 正片

逆袭女神
2017 | 正片

末法王座之封印
2017 | 正片
豆瓣:3.1分

冒牌监护人之寻宝闹翻天
2017 | 正片
豆瓣:6.5分

猫姑娘
2017 | 正片

千世千寻·珏
2017 | 正片
豆瓣:7.7分

美国民谣
2017 | 正片
豆瓣:6.4分

明亮的夜
2017 | 正片

玛门契约之涩爱诡局
2017 | 正片
豆瓣:2.7分

玛格丽特的春天
2017 | 正片

七仙女之勤奇梳化
2017 | 正片

麻香楼之造梦先生
2017 | 正片

马扁马扁之路子
2017 | 正片
豆瓣:7.0分

龙虎少年
2017 | 正片
豆瓣:7.9分

柯达克罗姆胶卷
2017 | 正片
豆瓣:5.3分

雷豹
2017 | 正片

浪客扳手侠
2017 | 正片

美女公寓
2017 | 正片

梦境生死劫
2017 | 正片
豆瓣:5.5分

咖啡风暴
2017 | 正片
豆瓣:6.2分

昆塔:反转星球
2017 | 正片
豆瓣:5.7分

军犬麦克斯2:白宫英雄
2017 | 正片
豆瓣:3.6分

老师也疯狂
2017 | 正片
豆瓣:4.4分

军火厂
2017 | 正片

莉莉的魔法圣诞节
2017 | 正片
豆瓣:7.0分

老兽
2017 | 正片
豆瓣:6.5分

老爸当家2
2017 | 正片

灵犀效应
2017 | 正片

零界之艾力克斯
2017 | 正片

流氓师姐
2017 | 正片
豆瓣:5.6分

科洛
2017 | 正片

镜头前的女人
2017 | 正片
豆瓣:4.5分

解谜者
2017 | 正片
看不见的敌人
2017 | 正片

君贺奇遇记
2017 | 正片

绝地游戏
2017 | 正片

克隆特工之极限对决
2017 | 正片

控梦师
2017 | 正片

绝境穿越
2017 | 正片
豆瓣:4.0分

坑爹游戏
2017 | 正片

极品桃花运
2017 | 正片
豆瓣:5.4分

记忆折叠
2017 | 正片

家庭之路
2017 | 正片

寂静的王国
2017 | 正片

疾风之赛道宝贝
2017 | 正片
豆瓣:3.7分

检查站
2017 | 正片

假想好友
2017 | 正片

胡媚娘
2017 | 正片

后宫太子妃
2017 | 正片
豆瓣:7.4分

小农夫
2017 | 正片
豆瓣:6.9分

果戈里·起点
2017 | 正片

红袖添香
2017 | 正片

诡影直播间
2017 | 正片

枪声响起
2017 | 正片

花开莱州
2017 | 正片

花腰恋歌
2017 | 正片
豆瓣:7.0分

霍姆斯之雨
2017 | 正片

花鼓情
2017 | 正片
豆瓣:3.2分

夺命五头鲨
2017 | 正片

画室惊魂
2017 | 正片

福运之人
2017 | 正片

帆船
2017 | 正片

逗逗迪迪之美梦年年
2017 | 正片

炒金男勇夺真爱
2017 | 正片

疯狂的行为艺术
2017 | 正片

东北三宝



